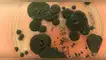
Científicos descubren hongo "come-radiación" que podría hacer posible la colonización espacial.

¡Sorprendente! Científicos rusos reviven planta de 32.000 años hallada en el hielo siberiano
Este reciente descubrimiento promete avanzar en la investigación y conservación de especies vegetales, transformando el cuidado de la biodiversidad.
Únete al canal de Whatsapp de El Popular- Ingenieros europeos imitan la estructura de los HONGOS para crear materiales de CONSTRUCCIÓN más eficientes y ecológicos
- Se acerca un posible apagón mundial y la NASA prepara una solución efectiva para proteger las redes eléctricas de la Tierra

La ciencia no deja de sorprendernos. Un reciente descubrimiento en Rusia ha impactado a la comunidad científica, pues se trata de un acontecimiento que consiste en devolver a la vida a una planta que estuvo extinta hace 32.000 años. Este resurgimiento botánico ha sido posible tras encontrar sus semillas, las cuales fueron conservadas durante la era de hielo.
¿Qué semillas encontraron los científicos rusos y cómo las conservaron?
Durante 2007, un equipo de investigadores encontró las semillas de la planta Silene stenophylla. Estas fueron halladas en el lugar menos pensado: en la madriguera de una ardilla de la zona. Esta revelación es considerada como el organismo vivo más antiguo del planeta.
Asimismo, los expertos sometieron a las semillas a una prueba de radiocarbono que reveló su edad, que era de unos 31.800 años, logrando superar a la antigua semilla de la palmera datilera de 2.000 años encontrada en Israel. La evidencia fue publicada en la revista Proceedings of the National Academy of Sciences.

¿Qué semillas encontraron los científicos rusos y cómo las conservaron?
Para su conservación, los científicos tenían que plantar nuevamente las semillas. No obstante, se demostró que al extraer el tejido placentario de frutos inmaduros era posible cultivarlos de forma in vitro. De esta manera, los expertos lograron cultivar hasta 36 plantas iguales, gracias a la clonación vegetal.
¿Qué beneficios trae el descubrimiento de esta planta para la ciencia?
El resurgimiento de la Silene stenophylla, lamentablemente, no presenta ningún tipo de beneficio médico para la salud humana. No obstante, su descubrimiento representa una perspectiva prometedora para la investigación y conservación de especies vegetales para el futuro.
Asimismo, se notaron cambios en el nuevo crecimiento de la planta, ya que resultaron ser mucho más fértiles, con pétalos mucho más largos y espaciosos, por lo que su germinación era del 100% efectiva. Sin duda, un hallazgo que cambiará el mantenimiento de especies para siempre, incluyendo las que convivimos en la actualidad.
Periodista especializada en ciencia, tecnología y salud. Bachiller en Periodismo de la Universidad Jaime Bausate y Meza. Redactora en El Popular, interesada en temas relacionados con estudios científicos, eventos astronómicos, hallazgos y más.